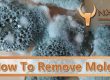
How To Remove Mold

How To Get Mold Out Of Car
Learn five techniques to rid your car of any mold growth.
1. Apply White Vinegar
Distilled white vinegar has been proven to work very well against mold growth. Due to this substance being mildly acidic, it kills mold spores, reducing their chances of returning. White vinegar is safe to use on many surface types, including leather and vinyl.
Follow These Steps:
- Dilute the vinegar bottle with water.
- Straight white vinegar can be applied to exceptionally moldy spots.
- Apply the vinegar to the moldy spots using either a spray bottle or cloth.
- Lightly scrub the area, then let the mixture sit for at least 20 minutes.
- Pick up the dead mold with a wet-and-dry vacuum cleaner.
2. Non-Iodized Salt
By drawing water out of their membranes, saltwater can efficiently dehydrate mold spores. This will end up starving and killing the spores completely. However, the salt needs to be in a solution, as it cannot be applied alone.
Follow These Steps:
- Start by vacuuming the area to rid the surface mold.
- Mix the salt in a bucket filled with water.
- Make sure the solution is concentrated enough to apply to the area.
- Apply the solution using a spray bottle or sponge.
- Allow the car time to dry out by leaving it in direct sunlight.
- A crusty residue should be left behind.
- Scrub off the remains with a vacuum cleaner.
- It’s okay to use water while running the vacuum cleaner.
3. Clove Oil
Clove oil fights mold by attacking spores, preventing any future growths. Use a quarter teaspoon of clove oil added to a liter of water.
Follow These Steps:
- Vacuum the affected area first.
- Mix the clove oil creating a solution.
- Apply a small amount of the solution to the mold.
- Once completely dry, clean the area.
4. Use Baking Soda
Baking soda is a terrific agent to use for fighting mold. As an added bonus, it can also act as an air freshener.
Follow These Steps:
- Sprinkle baking soda onto the mold.
- Let it sit for at least 20 minutes.
- Baking soda will soak up any excess moisture, which will result in a powdery residue.
- Try combining baking soda with white vinegar for better results.
5. Special Cleaning Agents
Investing in special cleaning agents to kill mold growth is a possibility, as well. Pay close attention to the ingredients, though, as some of these agents can contain toxic chemicals. Always make sure the products are safe for application on the desired surface.
Native Environmental LLC In Phoenix, Arizona
Native Environmental LLC is a industrial cleaning company located in Phoenix, Arizona offering a full list of industrial cleaning services including mold removal/remediation, asbestos removal/remediation, mercury spill clean up, silo cleaning and more. We can also help with industrial cleaning in Tempe, Tucson, Chandler, Gilbert, Glendale, South Phoenix, Central Phoenix, Scottsdale, Arizona and more.